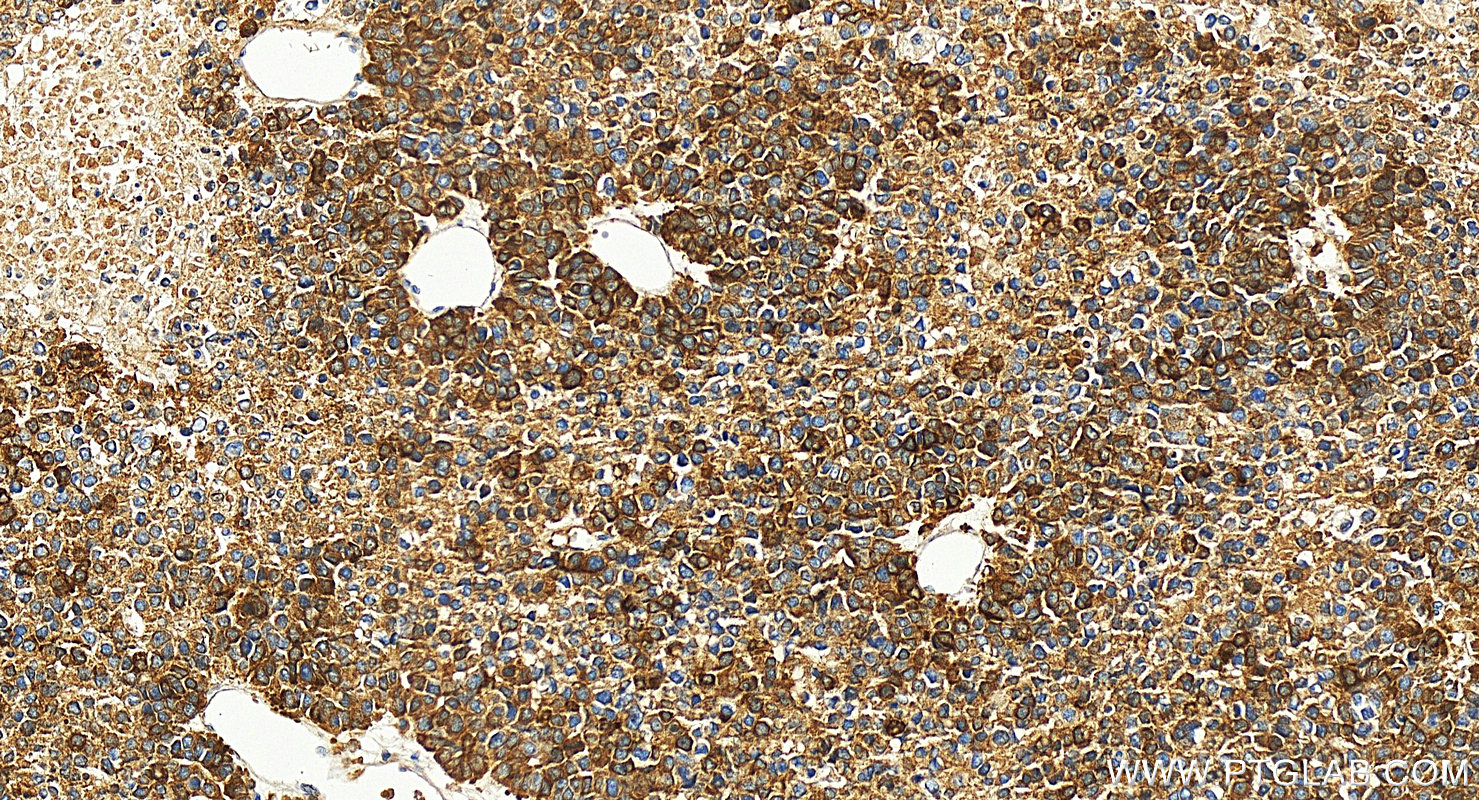
Immunohistochemical analysis of paraffin-embedded human Hepatocellular carcinoma slide using 26978-1-AP (DCDC2 antibody) at dilution of 1:2000 (under 20x lens). Heat mediated antigen retrieval with Tris-EDTA buffer (pH 9.0). IHC staining of human Hepatocellular carcinoma using 26978-1-AP

验证数据展示
经过测试的应用
| Positive WB detected in | mouse placenta tissue, HepG2 cells |
| Positive IHC detected in | human Hepatocellular carcinoma Note: suggested antigen retrieval with TE buffer pH 9.0; (*) Alternatively, antigen retrieval may be performed with citrate buffer pH 6.0 |
| Positive IF-P detected in | human liver cancer tissue |
推荐稀释比
| 应用 | 推荐稀释比 |
|---|---|
| Western Blot (WB) | WB : 1:500-1:2000 |
| Immunohistochemistry (IHC) | IHC : 1:1000-1:4000 |
| Immunofluorescence (IF)-P | IF-P : 1:50-1:500 |
| It is recommended that this reagent should be titrated in each testing system to obtain optimal results. | |
| Sample-dependent, Check data in validation data gallery. | |
产品信息
26978-1-AP targets DCDC2 in WB, IHC, IF-P, ELISA applications and shows reactivity with human, mouse samples.
| 经测试应用 | WB, IHC, IF-P, ELISA Application Description |
| 文献引用应用 | WB, IHC, IF |
| 经测试反应性 | human, mouse |
| 文献引用反应性 | human, mouse, rat |
| 免疫原 |
CatNo: Ag25577 Product name: Recombinant human DCDC2 protein Source: e coli.-derived, PGEX-4T Tag: GST Domain: 351-476 aa of BC050704 Sequence: EDGEKANKDAEQKEDFSGMNGDLEEEGGREATDAPEQVEEILDHSEQQARPARVNGGTDEENGEELQQVNNELQLVLDKERKSQGAGSGQDEADVDPQRPPRPEVKITSPEENENNQQNKDYAAVA 种属同源性预测 |
| 宿主/亚型 | Rabbit / IgG |
| 抗体类别 | Polyclonal |
| 产品类型 | Antibody |
| 全称 | doublecortin domain containing 2 |
| 别名 | DCDC2A, Doublecortin domain-containing protein 2, Protein RU2S, RU2, RU2S |
| 计算分子量 | 476 aa, 53 kDa |
| 观测分子量 | 52 kDa |
| GenBank蛋白编号 | BC050704 |
| 基因名称 | DCDC2 |
| Gene ID (NCBI) | 51473 |
| RRID | AB_2880709 |
| 偶联类型 | Unconjugated |
| 形式 | Liquid |
| 纯化方式 | Antigen affinity purification |
| UNIPROT ID | Q9UHG0 |
| 储存缓冲液 | PBS with 0.02% sodium azide and 50% glycerol, pH 7.3. |
| 储存条件 | Store at -20°C. Stable for one year after shipment. Aliquoting is unnecessary for -20oC storage. |
背景介绍
DCDC2 (Doublecortin domain-containing protein 2), also known as KIAA1154. DCDC2 is expressed in the central nervous system of adults and fetuses, especially in the olfactory cortex, inferior temporal cortex, medial temporal cortex, hypothalamus, amygdala and hippocampus. DCDCDC2 protein contains two dicortical protein domains that bind to microtubules and enhance microtubule polymerization, which may play a role in neuronal migration and affect the signal transduction of primary cilia. In addition, DCDC2 also plays a role in inhibiting classical WNT signaling. DCDC2 may affect the development and function of the brain by affecting the migration of neurons and the signal conduction of primary cilia, and then it is related to reading ability (PMID: 21457949). The molecular weight of DCDC2 is 52 kDa, it also has another isoform with a molecular weight of 25 kDa.
实验方案
| Product Specific Protocols | |
|---|---|
| IF protocol for DCDC2 antibody 26978-1-AP | Download protocol |
| IHC protocol for DCDC2 antibody 26978-1-AP | Download protocol |
| WB protocol for DCDC2 antibody 26978-1-AP | Download protocol |
| Standard Protocols | |
|---|---|
| Click here to view our Standard Protocols |
发表文章
| Species | Application | Title |
|---|---|---|
Physiol Genomics Polycystin-2-dependent transcriptome reveals early response of autosomal dominant polycystic kidney disease | ||
Sci Rep DCDC2 inhibits hepatic stellate cell activation and ameliorates CCl4-induced liver fibrosis by suppressing Wnt/β-catenin signaling | ||
Front Immunol TAK1 inhibition mitigates intracerebral hemorrhage-induced brain injury through reduction of oxidative stress and neuronal pyroptosis via the NRF2 signaling pathway |